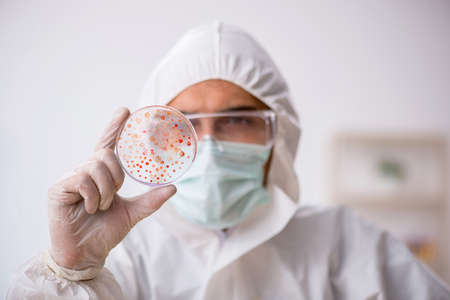
Young male chemist in drugs synthesis conceptの写真素材

写真素材 - Young male chemist in drugs synthesis concept
キーワード
- analysis
- analyzing
- bacteria
- biochemical
- biochemist
- biochemistry
- biology
- biotechnology
- blood
- chemical
- chemist
- chemistry
- diagnostic
- discovery
- dish
- doctor
- examining
- experiment
- experimenting
- face-mask
- glass
- health
- healthcare
- lab
- laboratory
- looking
- man
- mask
- medicine
- microbes
- microbiology
- petri
- pharmaceutical
- pharmacist
- pharmacology
- pharmacy
- research
- researcher
- sample
- science
- scientific
- scientist
- solution
- student
- substance
- test
- testing
- tubing
- vaccine
- virus
類似作品
Portrait of a h...
Speed and accur...
Organizing all ...
Creative expres...
Professional as...
Doctor at farma...
Pharmacist Of A...
Portrait of mal...
A focused scien...
a male pharmaci...
A dedicated pha...
A scientist in ...
Serious young p...
A chemist in a ...
Doctor at farma...
Browsing for hi...
Male doctor in ...
Pharmacist chec...
Male young scie...
An intently foc...
A man wearing a...
A young scienti...
Portrait of a y...
Close-up rear v...
Smiling Pharmac...
Woman Peering I...
Professional as...
Young male chem...
Handsome pharma...
A young student...
A man sits at a...
portrait of a y...
Portrait of tho...
Black doctor af...
Handsome pharma...
Chemistry stude...
A healthcare wo...
young guy choos...
Man doctor chec...
Funny male chem...
Young pharmacis...
portrait of a y...
Smiling pharmac...
Scientist Worki...
Young pharmacis...
Guy pharmacist ...
Young dentist w...
young, male res...
Doctor at farma...